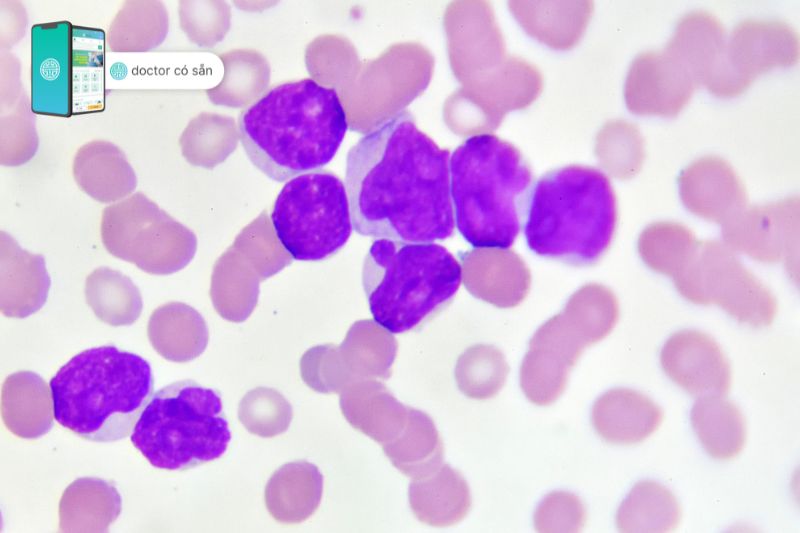

Bệnh bạch cầu hiện nay vốn là bệnh lý khó có thể chữa khỏi nhưng nhờ sự phát triển của y học hiện đại, phương pháp điều trị tiên tiến, can thiệp y tế kịp thời giúp mở ra nhiều hy vọng giành lại sự sống cho các bệnh nhân mắc phải căn bệnh hiểm nghèo này. Vậy, bệnh bạch cầu nguy hiểm như thế nào, phương pháp điều trị ra sao? Hãy cùng Doctor có sẵn tìm hiểu qua bài viết này.

Tóm tắt nội dung
- 1 Bệnh bạch cầu là bệnh gì?
- 2 Nguyên nhân dẫn đến bệnh bạch cầu
- 3 Triệu chứng bệnh bạch cầu
- 4 Điều trị bệnh bạch cầu ở đâu?
- 5 Bệnh bạch cầu cấp nguy hiểm như thế nào?
- 6 Chẩn đoán bệnh bạch cầu
- 7 Phương pháp điều trị bệnh bạch cầu
- 8 Lưu ý chăm sóc và điều trị cho người bệnh bạch cầu
- 9 Câu hỏi thường gặp
Bệnh bạch cầu là bệnh gì?
Bệnh bạch cầu hay bạch cầu cao là bệnh gì và có phải là bệnh nan y khó trị? Đây cũng là thắc mắc của nhiều bệnh nhân khi mới nghe qua căn bệnh này và nếu chưa tìm hiểu kỹ về căn bệnh này, chỉ nghe qua những thông tin tiêu cực sẽ khiến tình trạng bệnh nhân trở nên xấu hơn, sức khỏe ngày càng suy giảm.
Để trả lời cho câu hỏi bệnh bạch cầu hay bạch cầu cao là bệnh gì? Thì trong y khoa, các nhà khoa học đã định nghĩa bệnh bạch cầu hay bạch cầu cao là một tình trạng bệnh ác tính hiểu nôm na là bệnh ung thư máu liên quan đến việc sản xuất quá nhiều bạch cầu chưa trưởng thành hoặc bất thường ở tế bào gốc (tủy xương), cuối cùng sẽ ngăn chặn việc sản sinh ra các tế bào máu bình thường và gây ra các triệu chứng liên quan đến thiểu sản tế bào máu.
Dựa trên các đặc điểm lâm sàng, hình thái học các bạch cầu bất thường, miễn dịch và di truyền thì bệnh bạch cầu được phân thành các loại và ước tính phân bố như sau:
- Bệnh bạch cầu dòng tủy (Acute myeloid leukemia, AML): 33%
- Bệnh bạch cầu cấp (Acute lymphoblastic leukemia, ALL): 11%
- Bệnh bạch cầu kinh dòng tủy (Chronic myeloid leukemia, CML): 15%
- Bệnh bạch cầu kinh dòng pympho (Chronic lymphocytic leukemia, CLL): 33%
- Các bệnh bạch cầu khác: 8%
Xét nghiệm chẩn đoán bệnh bạch cầu tại phòng khám hay bệnh viện đáng tin cậy:
Ước tính rằng ở Hoa Kỳ năm 2022 có khoảng 61.000 trường hợp mắc bệnh bạch cầu (ở tất cả các loại) trên người lớn và trẻ em, đồng thời có khoảng 24.000 ca tử vong khi mắc phải căn bệnh nan y này.
Theo các thống kê mới nhất ở châu Âu, tỷ lệ mắc bệnh bạch cầu cấp trong cộng đồng hiện nay tăng cao so với thống kê của 10 năm trước; từ 3 – 5 người/100.000 người dân đến 8 – 9 người/100.000 người dân. Đồng thời chiếm khoảng 5% tổng số ung thư ở mọi lứa tuổi. Tỷ lệ mắc bệnh giữa nam/nữ khoảng 1,5/1.
Nguyên nhân dẫn đến bệnh bạch cầu
Cho đến nay, các nhà nghiên cứu vẫn đang tìm những nguyên nhân cụ thể gây ra bệnh bạch cầu. Một số nguyên nhân hiện nay có thể giải thích cho căn bệnh này, bao gồm:
- Hóa chất: Các hợp chất alkyl, chất ức chế topoisomerase II, hợp chất benzen như toluen, xylen,… gây ra các đột biến trên vật chất di truyền, hệ tạo máu gây nên bệnh bạch cầu.
- Tia bức xạ hay tia ion hóa: Tỷ lệ bệnh bạch cầu gặp nhiều ở những người tiếp xúc với tia bức xạ lâu ngày như tia UVA, UVB, tia X, tia gamma,… hay ở trong vùng nhiễm xạ nặng (lò phản ứng hạt nhân,…).
- Virus: Nhiều nghiên cứu ghi nhận một số virus gây bệnh trên người một thời gian dài gây ung thư. Ví dụ: HTLV1,2 gây bệnh bạch cầu cấp dòng lympho T,…
- Yếu tố di truyền: Một số các đột biến di truyền liên quan đến DNA, nhiễm sắc thể gây các bệnh bẩm sinh như hội chứng Down, hội chứng thiếu hụt miễn dịch bẩm sinh, hội chứng Poland, thiếu máu Fanconi, hội chứng Li – Fraumeni… gây người bệnh dễ mắc thêm bệnh bạch cầu.
- Yếu tố môi trường: Mỗi trường bị ô nhiễm các hóa chất, thuốc trừ sâu, phân bón, bảo vệ thực vật, tia xạ hạt nhân, tia từ thiết bị điện tử,… gây nên tình trạng nhiễm độc nguồn nước, thức ăn và gây nên các đột biến gen, nhiễm sắc thể trong di truyền cũng gây ra bệnh bạch cầu (ung thư máu).
Xét nghiệm chẩn đoán bệnh bạch cầu tại phòng khám hay bệnh viện đáng tin cậy:

Triệu chứng bệnh bạch cầu
Những triệu chứng bệnh bạch cầu phổ biến có thể thường thấy nhất như:
- Bệnh nhân thường xuyên bị sốt, nhức đầu, đau khớp thường lặp lại trong một thời gian dài.
- Người bệnh thường hay bị cảm lạnh, cảm thấy mệt mỏi, sụt cân mà không rõ nguyên nhân, khó thở yếu sức và da chuyển từ vàng sang trắng nhạt. Biểu hiện này là do lượng hồng cầu trong máu thiếu hụt.
- Dễ bị nhiễm trùng do tình trạng bạch cầu không bình thường sản sinh ra nhiều.
- Hay bị chảy máu chân răng, người dễ bị bầm tím. Điều này là do khả năng đông máu bị giảm xuống.
- Nếu bệnh nhân là nữ thì dễ ra mồ hôi về đêm.
- Xuất hiện những đốm đỏ trên da trong thời gian ngắn và phát triển nhanh thường do lượng tiểu cầu giảm, khiến cản trở việc đông máu gây xuất huyết dưới da.
- Sưng hạch bạch huyết và chảy máu cam.
Xét nghiệm chẩn đoán bệnh bạch cầu tại phòng khám hay bệnh viện đáng tin cậy:

Điều trị bệnh bạch cầu ở đâu?
Dưới đây là một số phòng khám, bệnh viện cung cấp dịch vụ thăm khám, điều trị bệnh bạch cầu chuẩn xác và hiệu quả có thể tham khảo:
Phòng khám Family Medical Practice
Phòng khám Family Medical Practice là hệ thống phòng khám tư nhân có vốn đầu tư nước ngoài tại Việt Nam được thành lập từ năm 1997 và hiện đang cung cấp các dịch vụ y tế theo chuẩn quốc tế, phục vụ hơn 30.000 bệnh nhân mỗi năm. Phòng khám ngoài được đầu tư trang thiết bị hiện đại cùng với đội ngũ bác sĩ từ Israel, Mỹ, Anh, Nhật, Ý, Pháp,… có nhiều kinh nghiệm trong cấp cứu, nội tổng quát, xét nghiệm chẩn đoán bệnh bạch cầu chuẩn xác như:
- Xét nghiệm kiểm tra công thức máu
- Xét nghiệm kiểm tra chức năng thận: Creatinine, BUN
- Xét nghiệm kiểm tra chức năng gan: SGOT, SGPT, ALP, GGT, Bilirubin, Albumin
Phòng khám Đa khoa Hoàn Mỹ Sài Gòn (Tân Bình)
Phòng khám Đa khoa Hoàn Mỹ Sài Gòn (Tân Bình) thuộc tập đoàn Chăm sóc Hoàn Mỹ đạt chứng nhận Six Sigma của Westgard VP – chứng nhận trong lĩnh vực xét nghiệm với kết quả xét nghiệm chính xác, bảo đảm chẩn đoán và điều trị đúng, đây là chương trình duy nhất trên thế giới thẩm định và xác nhận tiêu chuẩn này trong xét nghiệm.
Hệ thống máy xét nghiệm máu, xét nghiệm sinh hóa, miễn dịch tự động hoàn toàn, được kết nối với hệ thống máy tính cho kết quả nhanh, đảm bảo chất lượng.
Bệnh viện Truyền máu Huyết học – Cơ sở 2
Từ năm 1975, Bệnh viện Truyền máu Huyết học – Cơ sở 2 đã có những bước phát triển không ngừng với sự phát triển của khoa học kỹ thuật tiến bộ trên thế giới. Ngoài chức năng lưu trữ, cung cấp máu, bệnh viện còn có ngân hàng tế bào gốc, lưu trữ hơn 2500 mẫu máu cuống rốn.
Ngày 15/7/1995, bệnh viện đã trở thành trung tâm ghép tủy đầu tiên của cả nước, đánh dấu bước ngoặt mới trong lịch sử phát triển y học nước nhà. Bên cạnh đó, bệnh viện có khoa Ghép tế bào gốc với khu vực cách ly vô trùng tuyệt đối đã cấy ghép thành công hơn 100 trường hợp các bệnh lý về máu ác tính, bệnh thiếu máu di truyền bẩm sinh và suy tủy.
Bệnh viện 108
Bệnh viện 108 có khoa Huyết học lâm sàng (A18) là khoa lâm sàng chuyên sâu, tuyến cuối của Quân đội về chuyên ngành Huyết học lâm sàng và nghiên cứu ứng dụng tế bào gốc tạo máu mang lại sự sống và niềm tin cho các bệnh nhân ung thư máu.
Trung bình mỗi tháng, khoa tiếp nhận khám, tư vấn, chẩn đoán cho hàng trăm lượt bệnh cùng với đó là cấp cứu trung bình hàng ngày khoảng 60 bệnh nhân cả nội trú và ngoại trú, đa phần các ca nặng từ tuyến dưới. Với trình độ chuyên môn vững vàng và kinh nghiệm dày dạn, đội ngũ y bác sĩ còn được giao phụ trách vận hành trung tâm ghép tế bào gốc tạo máu mở ra cơ hội kéo dài sự sống cho các bệnh nhân mắc bệnh bạch cầu (ung thư máu).
Bệnh bạch cầu cấp nguy hiểm như thế nào?
Bệnh bạch cầu cấp là tình trạng bệnh lý các tế bào tạo máu bị ung thư hóa trong quá trình sản sinh ra các tế bào máu mới nhân lên rất nhanh. Nếu không được điều trị, các tế bào ung thư này sẽ ứ đọng trong tủy xương và cản trở sản sinh tế bào máu bình thường.
Các tế bào ung thư có thể di căn sang các cơ quan khác gây nên hàng loạt các triệu chứng khác nhau. Bệnh bạch cầu cấp có thể tiến triển nhanh và gây tử vong trong vòng vài tuần đến vài tháng nếu không được điều trị kịp thời.
Chẩn đoán bệnh bạch cầu
Dấu hiệu bệnh bạch cầu trên lâm sàng
Ở bệnh bạch cầu, do tủy xương không sản xuất đủ số lượng tế bào máu bình thường cho cơ thể dẫn đến hàng loạt các dấu hiệu bệnh bạch cầu trên lâm sàng dễ nhận thấy như sau:
- Dấu hiệu thiếu máu do giảm số lượng hồng cầu ảnh hưởng đến quá trình vận chuyển oxy đến các cơ quan đích trong cơ thể, gây ra chứng thở nhanh, thở ngắn khi vận động, hoa mắt, chóng mặt, mệt mỏi. Da, niêm mạc mắt, miệng nhợt nhạt.
- Dấu hiệu xuất hiện chảy máu do suy giảm số lượng tiểu cầu khi gặp các chấn thương nhẹ, những chấm xuất huyết nhỏ dưới da, hay chảy máu từ lợi và mũi. Trong một số trường hợp nặng có thể gặp xuất huyết nội tạng.
- Do sự tăng sinh quá mức các tế bào máu dẫn đến sự phì đại các cơ quan nội tạng như gan, lách, hạch.
Xét nghiệm chẩn đoán bệnh bạch cầu tại phòng khám hay bệnh viện đáng tin cậy:
Chẩn đoán bệnh bạch cầu trên cận lâm sàng
Xét nghiệm tế bào máu
Trong bệnh bạch cầu, các tế bào máu bất thường có thể quan sát được. Số lượng bạch cầu có thể tăng hoặc giảm, số lượng tiểu cầu giảm. Trong một số trường hợp, có thể quan sát tế bào ung thư máu ở mạch máu ngoại vi.
Xét nghiệm tủy xương
Chọc dò hút tủy xương là phương pháp lấy một ít mô tủy dưới dạng dịch lỏng để xác định sự có mặt của các tế bào ung thư máu, yếu tố quyết định để chẩn đoán bệnh bạch cầu.
Xét nghiệm sinh hóa huyết thanh & nước tiểu
Xét nghiệm này sẽ phân tích các thành phần trong máu và nước tiểu. Nồng độ acid uric trong huyết tương và nước tiểu sẽ tăng khi mắc bệnh này,, đồng thời nồng độ LDH cũng tăng trong trường hợp này.
Quan sát hình thái tế bào máu
Chuẩn bị tiêu bản máu để quan sát hình thái các tế bào máu. Dung dịch nhuộm Giemssa thường được dùng để nhuộm tiêu bản. Nhuộm đặc biệt như Peroxydase, Enterase không đặc hiệu và PAS thường được sử dụng để xếp thể bệnh bạch cầu cấp.

Xét nghiệm phân loại tế bào – kháng nguyên bề mặt tế bào
Phương pháp này giúp xác định các kháng nguyên trên bề mặt tế bào máu nghi ác tính thể hiện đặc trưng cho từng dòng tế bào ung thư máu chuyên biệt.
Kiểm tra bất thường yếu tố di truyền
Đây là phương pháp giúp kiểm tra những bất thường, đột biến ở các đoạn DNA và nhiễm sắc thể có thể được tìm thấy ở những tế bào bạch cầu ác tính.
Phương pháp điều trị bệnh bạch cầu
Phương pháp điều trị bệnh bạch cầu sẽ phụ thuộc vào từng loại bệnh, bệnh bạch cầu cấp tính hay mãn tính.
Hóa trị
Đối với một số bệnh bạch cầu, liệu pháp đầu tiên là hóa trị, sử dụng các loại thuốc tiêu diệt tế bào ung thư. Thuốc điều trị đầu tiên sẽ là thuốc nhắm mục tiêu (chất ức chế tyrosine kinase, chất ức chế FLT3) có đặc tính di truyền riêng biệt của tế bào ung thư. Các loại thuốc khác bao gồm:
- Các kháng thể để khuếch đại phản ứng của hệ thống miễn dịch đối với tế bào ung thư.
- Các tác nhân biệt hóa để giúp các tế bào máu trưởng thành: Acid all-trans-retinoic (ATRA), Asen trioxide (ATO),…
- Các yếu tố tăng trưởng kích thích sản sinh hồng cầu trong tủy xương.
- Các thuốc ức chế các tế bào bạch cầu phát triển: Chlorambucil, Cyclophosphamide,…
- Thuốc ức chế tế bào ung thư phân chia thành tế bào ung thư mới: Vincristin, methotrexate, 6 – mercaptopurine,…
- Thuốc tấn công và tiêu diệt các tế bào ung thư: Doxorubicin, Daunorubicin, Epirubicin,…
Xạ trị
Xạ trị chỉ được sử dụng trong các trường hợp khối u đã hình thành hoặc đã di căn đến hệ thần kinh trung ương. Xạ trị cũng được dùng để tiêu diệt các tế bào tủy xương bất thường chuẩn bị cho việc cấy ghép tế bào gốc.
Xét nghiệm chẩn đoán bệnh bạch cầu tại phòng khám hay bệnh viện đáng tin cậy:
Phẫu thuật
Bệnh bạch cầu thường khiến gan và lá lách to ra, vì vậy trong một số trường hợp hiếm hoi, lá lách to có thể cần phải được phẫu thuật cắt bỏ.
Ghép tủy
Khi các loại thuốc điều trị bệnh bạch cầu không thể kiềm chế được ung thư, phương pháp cấy ghép tế bào gốc được sử dụng để thay thế các tế bào gốc tủy xương bị ung thư bằng các tế bào gốc khỏe mạnh.
Liệu pháp tế bào T CAR
Hệ thống miễn dịch cơ thể sẽ chống lại các tế bào ung thư bạch cầu trong máu và tủy xương. Liệu pháp tế bào T CAR bao gồm việc loại bỏ các tế bào T khỏi máu. Các tế bào T sau đó được thay đổi di truyền. Các tế bào T bị thay đổi sẽ được nuôi trong phòng thí nghiệm và cấy lại vào máu để chống lại các tế bào ung thư bạch cầu trên khắp cơ thể.
Lưu ý chăm sóc và điều trị cho người bệnh bạch cầu
Hiện nay, đa số những bệnh nhân mắc bệnh ung thư chỉ tập trung vào điều trị chứ chưa quan tâm trọng điểm đến chế độ dinh dưỡng để nâng cao sức khỏe chống chịu với bệnh tật và liệu pháp chữa trị gây hao tổn thể lực. Do đó, đối với bệnh nhân mắc bệnh bạch cầu chế độ ăn hàng ngày cần chú ý:
- Chia nhỏ bữa ăn hàng ngày từ 5 – 6 buổi giúp hấp thu dưỡng chất tốt hơn đồng thời đồng thời tránh các tác dụng phụ sau khi điều trị như buồn nôn, nôn, đầy bụng chán ăn, mệt mỏi,…
- Cung cấp nước đủ từ 1,5 – 2 lít mỗi ngày giúp cơ thể chuyển hóa tốt hơn.
- Bổ sung đầy đủ các dưỡng chất cho người bệnh như:
- Protein: Được cung cấp từ các thực phẩm như thịt gà, trứng, sữa, tôm, cá, đậu,…
- Tinh bột: Nên chọn các loại ngũ cốc nguyên hạt như ngô, lúa mì, lúa mạch, đậu, các loại củ như khoai lang, khoai sọ, sắn,…
- Chất béo: Nên chọn các loại chất béo tốt cho sức khỏe như dầu oliu, dầu cá, dầu hướng dương, dầu quả bơ,…
- Vitamin và khoáng chất: Có nhiều trong các loại rau củ và trái cây, ngoài ra các loại thực phẩm này còn giúp chống oxy hóa chống lại tế bào ung thư. Các loại rau quả tốt cho bệnh bạch cầu như cam, nho, bơ, cà chua, súp lơ, củ dền, bí đỏ,…
- Thực hiện ăn chín uống sôi là một trong những nguyên tắc trong chế độ ăn người mắc bệnh bạch cầu vì những vi khuẩn, độc tố có hại trong các thực phẩm chưa nấu chín có thể làm tăng nguy cơ nhiễm trùng, ngộ độc ở những người mắc bệnh này.
- Tránh cho bệnh nhân ăn các thực phẩm có gia vị chua, cay nồng, thực phẩm cứng, có góc cạnh sắc gây khó nhai, nuốt; những đồ uống chứa chất kích thích chứa cafein,…
Xét nghiệm chẩn đoán bệnh bạch cầu tại phòng khám hay bệnh viện đáng tin cậy:

Câu hỏi thường gặp
Bệnh bạch cầu chữa khỏi được không?
Bệnh bạch cầu không thể chữa khỏi, tuy nhiên nhờ sự tiến bộ y khoa thì kết quả điều trị bệnh được cải thiện đáng kể.
Bệnh bạch cầu cấp dòng tủy sống được bao lâu?
Những người được chẩn đoán ở giai đoạn đầu có thể sống trung bình được 8 năm, chẩn đoán giai đoạn giữa trung bình sống được 5,5 năm. Còn chẩn đoán ở giai đoạn cuối chỉ sống được gần 4 năm.
Bệnh bạch cầu có nguy hiểm không?
Bệnh bạch cầu là một trong những bệnh lý về máu nguy hiểm trực tiếp đến tính mạng người bệnh.
Hi vọng thông qua bài viết này, các bạn đã có nhiều thông tin bổ ích về căn bệnh bạch cầu, hiểu được mối nguy hiểm cũng như các phương pháp điều trị y khoa hiện nay để có thể cải thiện sức khỏe, kéo dài sự sống khi mắc phải bệnh này. Nếu bạn hoặc người thân của bạn có những dấu hiệu trên hoặc đang mắc bệnh bạch cầu, xin vui lòng đặt lịch khám với bác sĩ chuyên khoa huyết học.
- https://www.msdmanuals.com/vi-vn/
- https://bthh.org.vn/74/benh-bach-cau-cap-leukemia-cap.html
- https://bthh.org.vn/74/tim-hieu-ve-benh-bach-cau-cap-ung-thu-mau-chan-doan-va-cach-chua-tri.html
- https://moh.gov.vn/chuong-trinh-muc-tieu-quoc-gia//5-trieu-chung-chinh-cua-benh-bach-cau?
- https://suckhoedoisong.vn/benh-bach-cau-la-gi-cac-phuong-phap-chua-tri-hieu-qua.htm
- https://www.benhvien108.vn/y-hoc-thuong-thuc/che-do-dinh-duong-cho-nguoi-benh-bach-cau-cap-dong-tuy.htm












